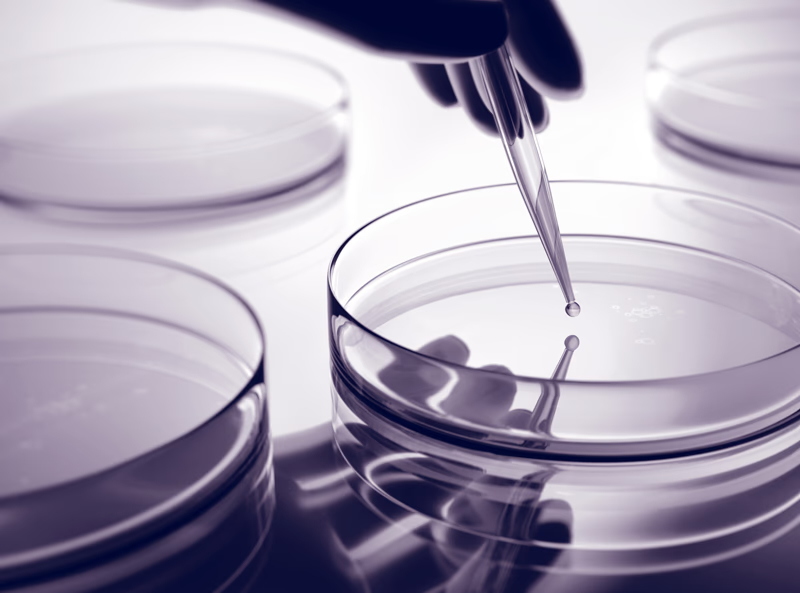

Nuclide Therapeutics sichert sich eine Investition von 5 Millionen Pfund von der Marathon Beteiligungs-AG
Nuclide Therapeutics Ltd (NTx), eine Ausgründung des King’s College London, die sich schwerpunktmäßig mit der Entwicklung von Radiopharmaka zur Behandlung therapieresistenter Krebserkrankungen beschäftigt, freut sich, den Abschluss ihrer ersten erfolgreichen Investitionsrunde in Höhe von 5 Millionen £ bekannt zu geben. Die meilensteingebundene Finanzierung wird von der Dresdener Marathon Beteiligungs-AG bereitgestellt. NTL erhält damit die bislang höchste vorgeldliche Bewertung aller Ausgründungen des King’s College London.
Die Finanzierung dient der Weiterntwicklung von NTx´ proprietärer Produktfamilie, die gegen den Tumor-Rezeptor ALDH1A1 gerichtet sind, der spezifisch Krebszellen zu identifizieren und zu eliminieren erlaubt, die resistent gegen konventionelle Therapien sind. Die Investition wird es NTx ermöglichen, seine führenden Wirkstoffkandidaten, für die bereits viel versprechende vorklinische Daten beim Lungen- und Eierstockkrebs vorliegen, in Phase I-Studien (humane Erstanwendung) zu überführen, die Anwendung bei bei weiteren Krebsarten evaluieren und die Entwicklung weiterer Entwicklungskandidate zu beschleunigen.
Dr. Muhammet Tanc, Mitbegründer und Vorstand von Nuclide Therapeutics, bemerkte dazu:
„Die Gründung von NTx ist ein wichtiger Schritt vorwärts auf unserer Mission, Patienten mit therapieresistenten Krebserkrankungen eine wirksame Behandlungsoption zu anzubieten. Der Abschluss der Finanzierungsrunde mit der Marathon Beteiligungs AG, verschafft uns nicht nur Kapital, sondern auch einen wirlichen Partner, der unsere Vision teilt. Gemeinsam schaffen wir ein Unternehmen, basierend auf wissenschaftlicher Exzellenz, translationalem Impakt und der Verbesserung des Lebens jener Menschen, die unsere Arbeit am dringendsten benötigen.“
Die Investition ist an definierte Entwicklungs- und regulatorische Meilensteine geknüpft und bietet NTx Flexibilität und strategische Orientierung bei der Vorbereitung IND-vorbereitender Studien (Investigational New Drug).
Dr. Andreas Kluge, Vorstand der Marathon Beteiligungs AG, erklärte:
„Als langjährige Marktbeobachter bauen wir auf überzeugende Ansätze und freuen uns, talentierten Gruppen wie der von NTx Möglichkeiten zur Weiterentwicklung ihrer Ideen bieten zu können.“
„Unser integrierter Investitionsansatz umfasst nicht nur die Bereitstellung finanzieller Ressourcen, sondern auch den Aufbau einer engen und vor allem fairen Partnerschaft in der wirtschaftlichen Entwicklung des Unternehmens“, ergänzt Matthias Untisz, CFO der Marathon Beteiligungs AG.
Nicolas Huber, Interim Direktor des King’s Innovation Catalyst, sagte:
„Wir freuen uns sehr über die bedeutende Finanzierung, die das erste Spin-out aus dem Labor von Prof. Witney erhalten hat. Dies ist ein starker Vertrauensbeweis für die wissenschaftliche Qualität und translationale Expertise des King’s College im Bereich Radiopharmaka, einschließlich der Theranostik. Das Team und der Gründungsinvestor sind Weltklasse, und wir freuen uns auf die Fortschritte von NTx mit ihren führenden Wirkstoffkandidaten bei nicht behandelbaren Tumoren – mit potenziell erheblicher Bedeutung für das Leben von Krebspatientinnen und -patienten weltweit.“